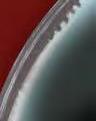

Сладоледена
















































































































































































































































































































































































































































































































































































































е а
ОТ ЧЕТВЪРТЪК 20.07. ДО 26.07.2023 г. *До 10 бр. на клиент на ден с BILLA Card от артикула, попадащ в акционната активност. При покупка над 10 бр., всеки следващ продукт се продава на регулярна цена. **До 12 бр. на клиент на ден с BILLA Card от артикула, попадащ в акционната активност. При покупка над 12 бр., всеки следващ продукт се продава на регулярна цена. Цените са валидни за целия период на брошурата, освен ако е указано друго вътре в нея. Посочените цени са в български лева с включен ДДС. -20% 949 Кафе капсули Dolce Gusto 88 - 187 г 1199 -50% 1049 Тоалетна хартия Papia 3 пласта 16 бр. в опаковка 2099 -52% 011 Грахам багета От BILLA пекарна 40 г 023 от качествени съставки -41% 099 Сладолед Galaxy 73 г 169 219 Бира Шуменско** 2 л До 12 бр. на клиент -22% 699 Сладолед мини класик BILLA 12 х 50 мл 899 -26% 1199 Краве сирене Саяна От деликатесната витрина За 1 кг 1629 11252250 Сладолед Familia Collection 495 - 523 г Цена за 1 бр. 11,25 лв. Цена за 2 бр. без отстъпка 22,50 лв. + -30% 799 Сладолед Carte D‘Or 900 мл 1149 26.07.20 -31% 1399 Ципура прясна Произход – Гърция Размер 300/400 За 1 кг 2039 229 Захар Захира* 1 кг цена без BILLA Card 2,69 До 10 бр. на клиент СЕГА В BILLA 079 Диня 1 кг Следвай ни: www.billa.bg




















Сладолед Ben & Jerry 465 мл -29% 10991549 Сладолед Milka 480 мл -40% 8991499 -29% 529 Сладолед сандвич BILLA 8 х 90 мл 749 Сладолед BILLA Premium 500 мл -33% 799 1199 -20% 055 Сладолед Clever 50 г 069 -32% 169 Сладолед Cool&Zero 50 г 249 -30% 699 Сладолед с бадеми JA! 6 х 120 мл 999 Сладолед BILLA 120 г -26% 169 229 Джелато Стик Gruvi 4 х 60 г -27% 7991099

























-25% 599 Сладолед BILLA 900 мл 799 -28% 499 Сладолед Everyday 900 мл 699 -38% 399 Сладолед Familia 345 г 649 -17% 549 Сладолед 3 вкуса Clever 2 л 669 Пурички Caprice 400 г -27% 699 959 Посочените цени са в български лева с включен ДДС. -26% 1099 Сладолед Old Time Шамфъстък 750 мл 1499 -36% 599 Сладолед Черноморец 900 мл 949 -31% 599 Сладолед Бурбонска ванилия JA! 1000 мл 869 -20% 349 Вафли Loacker Thins 150 г 439














































































































% % В % % -24% 139 Кисело мляко 5% Верея Чудно 400 г 185 -20% 999 Свински врат с кост нарязан За 1 кг 1249 -20% 199 Софийска права баница със сирене От BILLA пекарна 170 г 249 от качествени съставки -50% 599 Старец Орехите 180 г 1199 -29% 119 Татарско кюфте От топлата витрина 1 бр. 169 -33% 399 Немско краве масло BILLA 250 г 599 -32% 1699 Кашкавал от краве мляко Булгарче От деликатесната витрина За 1 кг 2499 -25% 299 Домати розови Ръгби BILLA Градини 1 кг 399 Градините в с. Първомай, гр. Петрич -33% 099 Сладка царевица BILLA градини 1 бр. 149 Градините в с. Ивайло, с. Милево -35% 649 Прясно пиле клас А Градус За 1 кг 999





























































% % % BILLA % Посочените цени са в български лева с включен ДДС. * До 24 бр. на клиент на ден с BILLA Card от артикула, попадащ в акционната активност. При покупка над 24 бр., всеки следващ продукт се продава на регулярна цена. -40% 1799 Маслиново масло Classico Extra Virgin Monini 1 л 2999 -28% 1299 Бонбониера Lindt Lindor 337 г 1829 -33% 059 Вафла Морени Mахх 49 г 089 -40% 059 Пауч за котки Master 80 г Различни видове 099 -25% 1499 Уиски Passport 0,7 л 1999 СЕГА В BILLA 3999 Филтри за вода Maxfor + Магнезий 6 бр. 099 Бира Astika кен * 0,5 л До 24 бр. на клиент -26% 109 Bake Rolls 80 г 149 -45% 379 Лютеница Хорцето 560 г 699 СЕГА В BILLA 1499 Гел за пране Persil 40/38 пранета или Дискове за пране Persil 22 бр. Различни видове 1 опаковка










































-33% 199 Корнишони BILLA градини 1 кг 299 -33% 199 Моркови 1 кг 299 -37% 499 Чесън 1 кг 799 Градините в с. Първомай, с. Милево -30% 279 Пиперки светлозелени BILLA градини 1 кг 399 Градините в с. Милево -30% 349 Кафява кралска печурка 500 г 499 свеж сандвич с краставица, пиле и авокадо ВИЖ РЕЦЕПТАТА ТУК Изненадай със













































Посочените цени са в български лева с включен ДДС. * Офертата е валидно от 20.07. до 23.07.2023 г. или до изчерпване на наличните количества. В BILLA -33% 199 Нектарини 1 кг 299 Градините в с. Медовина -28% 249 Малини BILLA градини 125 г 349 -28% 179 Пъпеш Галия* 1 кг 249 -35% 259 Лимони 1 кг 399 СЕГА В BILLA 199 Сини сливи Блек Амбър 1 кг Офертата е валидна от 20.07. до 23.07.2023 г.
Сготви вкусна












лазаня с рагу от













и бамя











заешко
-16% 499 Кайма смес от агнешко и телешко месо Деком 500 г 599 -22% 699 Пилешко филе жулиени мариновани МК Свилeнград 500 г 899 -17% 1199 Мариновани свински ребра Spare За 1 кг 1449 -15% 549 Суджук от свинско месо за сушене и скара Grill Party 500 г 649 -23% 1299 Охладен заек За 1 кг 1699
ВИЖ РЕЦЕПТАТА ТУК





































Посочените цени са в български лева с включен ДДС. В BILLA -20% 899 Свински гирос замразен En Elladi 330 г 1125 -35% 359 Филе маринована херинга лимон или пикантно Salmaris 220 г 559 -25% 749 Дива сьомга филе замразена BILLA 250 г 999 -45% 229 Разбит хайвер натурален или по гръцки Ocean Pick 160 г 419 -20% 799 Сьомга слайс студено-пушена Mowi 100 г 999

















































































































-28% 199 Хляб микс от семена От BILLA пекарна 400 г 279 -20% 279 Хляб Вита Фитнес 400 г 349 -17% 115 Донът с шоколадов пълнеж или с ванилов пълнеж 71 г 139 -25% 119 Закуска с топено сирене От BILLA пекарна 110 г 159 -22% 069 Охлювче с канела От BILLA пекарна 70 г 089 от качествени съставки -28% 049 Мини сомун От BILLA пекарна 120 г 069 В BILLA -17% 289 Тортила питка El Sabor 245 г 349 прясно изпечено хлебче Към грил обяда добави










































































Посочените цени са в български лева с включен ДДС. Изобилие от вкусни грил ястия и гарнитури -29% 269 Печен суджук От топлата витрина 1 бр. 379 В BILLA -23% 689 Картофи с копър и чесън От топлата витрина За 1 кг 899 -16% 1499 Спагети с четири сирена От топлата витрина За 1 кг 17 99 -17% 1399 Броколи със сирене и сос От топлата витрина За 1 кг 1699 -15% 1099 Пиле с ориз От топлата витрина За 1 кг 1299 -17% 1399 Имамбаялдъ От топлата витрина За 1 кг 1699 -31% 239 Печено пилешко бутче Българска ферма От топлата витрина 1 бр. 349






























































































НАШИТЕ МАРКИ * Офертата е валидна от 20.07.2023 г. до 26.07.2023 г. Само с BILLA Card. Офертата не се прилага за продукти от седмични акции (червени цени) и други стоки с намалени цени, както и за артикули с етикет „Сега в BILLA“. Отстъпката получаваш веднага на каса. Изображенията са илюстративни. Луканка слайс BILLA 100 г -18% 349 429 Деликатес с пуешко слайс Clever 200 г -40% 349 589 Прошуто Крудо слайс BILLA 90 г -20% 399 499 Телешки суджук Орехите 160 г -33% 799 1199 Салам Бургас Кен 200 г -25% 449 599 Варена шунка Браво 820 г -20% 8691099 Колбас Телешки или Камчия Тандем 300 г -21% 429 549 1499 Деликатес с пуешко филе Майстор Цветко От деликатесната витрина За 1 кг цена без BILLA Card 23,89 599 Краковски салам Мес-ко 210 г цена без BILLA Card 7,79 Свинска шунка слайс Clever 100 г -23% 199 259 -20% колбасиНавсичкисмаркаЕКОМЕС* СПЕЦИАЛНАОФЕРТА






































































Посочените цени са в български лева с включен ДДС. ** Номерацията показва броя маслини в един килограм. В BILLA -37% 899 Македонска наденица Народен От деликатесната витрина За 1 кг 1449 1099 Разбит салатен хайвер От деликатесната витрина За 1 кг 1699 Печени чушки От деликатесната витрина За 1 кг цена без BILLA Card 19,99 599 Снежанка Оливие От деликатесната витрина За 1 кг 689 -43% 899 Зелени маслини без костилка с подправки От деликатесната витрина За 1 кг 1599 -32% 599 Черни маслини Услу 240-280** От деликатесната витрина За 1 кг 889 -30% 2399 Салам Амбарица Бони От деликатесната витрина За 1 кг 3449 -27% 2599 Чешка шунка Тандем От деликатесната витрина За 1 кг 3599 -38% 799 Тиквички със специален сос От деликатесната витрина За 1 кг 1299 1899 Шпек Перелик От деликатесната витрина За 1 кг цена без BILLA Card 29,89 2599 Луканкови пръчици Бони От деликатесната витрина За 1 кг цена без BILLA Card 35,99


















































НАШИТЕ МАРКИ -21% 469 Маскарпоне Marca Italia 250 г 599 Десерт с шоколадова глазура BILLA 30 г -24% 075 099 -20% продуктиНавсичкисмарка BELLAиФАМИЛИЯ* СПЕЦИАЛНАОФЕРТА -20% продуктиНавсичкиACTIVIAсмарка * СПЕЦИАЛНАОФЕРТА Прясно мляко 3% Саяна 1 л -29% 219 309 -27% 1299 Кашкавал от краве мляко Дряново За 1 кг 1790 -18% 899 Краве сирене Тракийка За 1 кг 1099 -24% 249 Сирене котидж 4,5% Landfrisch 150 г 329 -25% 299 Крем сирене за мазане Arla 200 г 399 -33% 299 Топено сирене слайс Clever 200 г 449 В BILLA -23% 449 Яйца от подово отглеждани кокошки Дончево размер M 10 бр. в опакoвка 589





























































НАШИТЕ МАРКИ Посочените цени са в български лева с включен ДДС. * Офертата е валидна от 20.07.2023 г. до 26.07.2023 г. Само с BILLA Card. Офертата не се прилага за продукти от седмични акции (червени цени) и други стоки с намалени цени, както и за артикули с етикет „Сега в BILLA“. Отстъпката получаваш веднага на каса. Изображенията са илюстративни. -20% Навсички продуктисмарка CHEFIS…* СПЕЦИАЛНАОФЕРТА -27% 519 Риба тон парче в собствен сос BILLA 3 х 80 г 719 Грах екстра фин BILLA 200 г -36% 139 219 -31% 189 Бульон Maggi 120 г 275 269 Русенско варено Compass 180 г цена без BILLA Card 3,49 Кетчуп оригинал Heinz 342 г -30% 299 429 Български ориз Кръстев 1 кг -40% 279 469 Неподсладени веган напитки Alpro 1 л Различни видове -28% 499 699 289 Скумрия Di Nea 310 г цена без BILLA Card 3,99 -33% 599 Кокосово масло BILLA BIO 250 г 899 Кокосово мляко BILLA 400 мл -28% 349 489
Плащай с Visa в Billa и



за:



Период на кампанията: от 13.07. до 30.09.2023 г. с три месечни подпериода: от 13.07. до 31.07., от 01.08. до 31.08. и от 01.09. до 30.09.2023 г. Всеки, платил в магазини BILLA с карта Visa (в т.ч. и с мобилно устройство) покупка на стойност поне 5 лв. в рамките на съответния подпериод на кампанията, може да спечели награда. В рамките на всеки подпериод ще бъдат раздадени 4 семейни вечери в ресторант Chef’s, 40 барбекюта Weber, 40 преносими барбекюта Weber и 40 BILLA ваучера. В

тегленето за награда за съответния месечен подпериод автоматично участват само плащания с карти Visa, издадени до 12.07.2023 г. вкл. от организация, която участва в кампанията. Виж официалните правила и списъка с участващи организации на visabg.com Повече на visabg.com
ЗА
ГОТВИ 120 барбекюта Weber 120 преносими барбекюта Weber 120 BILLA ваучера за пазаруване на стойност 200 лв. (на шеф Виктор Ангелов) 12 семейни вечери на стойност до 500 лв. в ресторант Chef’s
участвай
СЕ
НАГРАДИ





























Мляно кафе Jacobs Monarch 250 г -37% 559 889 Разтворимо кафе Tchibo Black & White 200 г -44% 999 1799 -30% 069 Кейк Milkiss 42 г 099 -26% 199 Шоколад Break 85 г 269 099 Шоколадов десерт Lion 2 pack 60 г 229 Сурови бадеми Rois 70 г НАШИТЕ МАРКИ -25% 021 Разтворима напитка 3в1 BILLA 18 г 028 Печени белени фъстъци без сол BILLA 200 г -23% 199 259 Екзотик микс BILLA 150 г -22% 349 449 В BILLA -41% 229 Чипс Chio Intense 130 г 389 Посочените цени са в български лева с включен ДДС. Оризови бисквити Rice up 120 г -29% 119 169











































Спиртна напитка Ямболска гроздова 0,7 л -25% 9491269 Водка Savoy 0,7 л -25% 899 1199 Джин Beefeater Pink 0,7 л -27% 19992755 Бирен микс Garage бутилка 0,4 л -24% 199 265 -20% 769 Енергийна напитка Red Bull 4 x 0,250 л 969 -27% 1599 Узо 12 0,7 л 2199 169 Бира Загорка 1 л 999 Вино JP. Chenet 0,75 л цена без BILLA Card 12,99 -20% 599 Сок 100% Ябълка BILLA градини 3 л 755 -41% 169 Изворна вода Devin 5 л 289 В BILLA -20% Намастикаимента смарка ПЕЩЕРА* СПЕЦИАЛНАОФЕРТА
















































Посочените цени са в български лева с включен ДДС. * Офертата е валидна от 20.07.2023 г. до 26.07.2023 г. Само с BILLA Card. Офертата не се прилага за продукти от седмични акции (червени цени) и други стоки с намалени цени, както и за артикули с етикет „Сега в BILLA“. Отстъпката получаваш веднага на каса. Изображенията са илюстративни. Бира Tuborg кен 0,5 л -31% 149 219 Бира Heineken кен 0,33 л -32% 145 215 Напитка на винена основа Frutino 0,75 л -28% 699 979 Бира Kozel светла кен 0,5 л -20% 199 249 Тенеси Уиски Jack Daniel‘s 1 л -17% 47995799 139 Студен чай Fuze Тea 0,5 л 1499 Водка Sobieski Superior 0,7 л 3099 Уиски Black Bush 0,7 л Студен чай Наслада макс 1,5 л -20% 079 099 -20% Навсички VILLAвинасмаркаYAMBOL* СПЕЦИАЛНАОФЕРТА Газирана напитка кен Coca Cola, Fanta, Sprite или Schweppes 0,33 л -27% 115 159 1 л





































Слънцезащитен спрей Бочко SPF 50 150 мл -25% 15992149 Защитно олио за допълнителен тен Nivea Sun Protect & Bronze SPF 30 200 мл -33% 16992549 Детски слънцезащитен спрей с помпа Nivea SPF 50+ 270 мл -38% 23993899 СЕГА В BILLA 599 Гел за след слънце Здраве Бебе 150 мл СЕГА В BILLA 1399 Спрей-олио за бърз тен Piz Buin Tan Protect SPF 15 150 мл Слънцезащитен спрей емулсия Здраве SPF 30 150 мл -33% 13992099 Oлио за бързо потъмняване Carroten 200 мл -35% 10991699 Охлаждащ спрей за след слънце Nivea After Sun 200 мл -31% 12991899 Слънцезащитно мляко Carroten SPF 50 270 мл -34% 22993499
























-20% 399 Гел след ухапване от насекоми Бочко 20 мл 499 СЕГА В BILLA 749 Лосион против ухапване от насекоми Бочко 120 мл Лосион против комари и кърлежи Derma+ Family 100 мл -29% 659 929 СЕГА В BILLA 999 Изпарител с ламинирани таблетки Raid дозатор + 10 бр. таблетки 1 опаковка -38% 999 Електрически изпарител с пълнител против комари Raid 21 мл 1629 • Универсален инсектицид Супер Килтокс 400 мл -25% 449 599 СЕГА В BILLA 399 Спирали против комари Bros 10 бр. в опаковка Посочените цени са в български лева с включен ДДС. Лосион или аерозол против ухапване от комари Autan Family 100 мл -35% 8991399
ВАЛИДНОСТ 13.07. ДО 26.07.2023 Г. СЕГА В BILLA 899 Електрически изпарител против комари за деца над 1 г. + 10 бр. таблетки Bros 1 опаковка
ДВУСЕДМИЧНА
Четка
за почистване
на прах








с телескопична
дръжка 65 см

за почистване








Четка за миене на бутилки 38,5 см
за почистване на съдове 5 бр.




Гъба за почистване *
3 бр. в опаковка



Четка











за почистване на термос бутилки 1 бр.

Четка за фуги 20 см







Чували за смет 120 л


Попивателни кърпи 5 бр.








Стъклочистачка* 24,5 х 22 см




































Почистваща спирала за тръби* 1 м
















Кърпа за почистване 35 х 35 см











или до изчерпване на
наличните количества.
5 бр. в опаковка
2 бр.




































279 Консерва за кучета Beta 1240 г Различни видове -44% 999 Автоматична помпа за вода 1 бр. цена без BILLA App 17,99 Кухненска ролка Zebra Professional 2 пласта 1 бр. -24% 529 699 Адаптирано мляко Hipp Combiotic 3 За деца над 1 година 500 г -16% 20292419 -48% 3389 Таблетки за съдомиялна Finish Power All in1 80 бр. в опаковка 6599 Спрей за почистване на баня Cif 500 мл -31% 459 669 НАШИТЕ МАРКИ -26% 109 Пастет за кучета ZooRoyal с пилешко или с говеждо 150 г 149 Попивателни гъби BILLA 5 бр. в опаковка -21% 259 329 Тоалетно блокче Clever 2 х 48 г -30% 269 389 -25% 299 Универсални почистващи мокри кърпи Citrus JA! 80 бр. в опаковка 399 Посочените цени са в български лева с включен ДДС. 659 Омекотител Semana 68 пранета СЕГА В BILLA






























































































































СЕГА В BILLA 1499 Сгъваем кош* 12 л Различни цветове СЕГА В BILLA 999 Сгъваема кофа* 10 л Различни цветове СЕГА В BILLA 1999 Сгъваем кош за пране* 17 л Различни цветове СЕГА В BILLA 1599 Ръкохватка Harry Potter или Peanuts 2 бр. СЕГА В BILLA 1599 Кухненска престилка Harry Potter или Peanuts 1 бр. СЕГА В BILLA 1499 Кухненски кърпи Harry Potter или Peanuts 3 бр. СЕГА В BILLA 2999 Тиган от 100% рециклиран алуминий Cooc 24 см СЕГА В BILLA 3999 Тиган от 100% рециклиран алуминий Cooc 28 см СЕГА В BILLA 3499 Тиган от 100% рециклиран алуминий Cooc 28 см * Офертата е валидна от 13.07. до 26.07.2023 г. или до изчерпване на наличните количества.





















































-48% 499 Паста за зъби Parodontax Ultra Clean 75 мл 969 В BILLA 489 Дезодорант спрей STR8 150 мл -20% Навсички продуктисмарка ASTERA* СПЕЦИАЛНАОФЕРТА -20% Навсичкипродукти смаркаGARNIERFRUCTIS, GARNIERCOLORNATURALS ИGARNIERDEOMINERAL* СПЕЦИАЛНАОФЕРТА Гел за бръснене Gillette 200 мл Различни видове -24% 849 1125 Душ гел Dove 450/500 мл -34% 799 1229 Депилиращ крем Veet 400 мл -27% 19992759 Посочените цени са в български лева с включен ДДС. * Офертата е валидна от 20.07.2023 г. до 26.07.2023 г. Само с BILLA Card. Офертата не се прилага за продукти от седмични акции (червени цени) и други стоки с намалени цени, както и за артикули с етикет „Сега в BILLA“. Отстъпката получаваш веднага на каса. Изображенията са илюстративни. СЕГА В BILLA 749 Подхранващ крем за лице Nivea Care 200 мл СЕГА В BILLA 449 Шампоан 400 мл или Балсам 250 мл Schauma 1 бр. 549 Четка за зъби Colgate 360 Black 2 бр. в опаковка 329 Ежедневни дамски превръзки Libresse 32 бр. в опаковка цена без BILLA Card 4,49
50% от цената


продукт с марка Weber, включен в кампанията. Артикулите Weber и конкретният размер отстъпка от продажната цена







YEAR LIMITED WARRANTY БАРБЕКЮ НА ВЪГЛИЩА Weber® Classic Kettle 47cm ПРЕНОСИМО БАРБЕКЮ НА ВЪГЛИЩА Weber® Go-Anywhere ПРОДУКТИТЕ НА WEBER ВСЕ ОЩЕ СА ТУК СЪБИРАЙ ТОЧКИ И ВЗЕМИ ОТСТЪПКА ДО -50% С * Всеки 10 лв. = 1 промоточка YEAR LIMITED WARRANTY *От 04.05.2023г. до 16.08.2023г. за всеки 10 лева от покупка с BILLA Card в магазини BILLA всеки клиент има право да получи 1 промоточка. Събери 10 (десет) промоточки и ги използвай с BILLA Card, за да получиш отстъпка до
на
може да видите в рекламните материали за кампания
Период на кампанията от 04.05.2023г. до 16.08.2023г. вкл. или до
количествата артикули Weber. Възможно е поради силно увеличено търсене в отделни дни някои артикули Weber временно да не са налични във всеки магазин BILLA. Виж пълните правила на кампанията във всеки магазин BILLA и на www.billa.bg. 372.00 лв цена без точки без BILLA Card 240.00 лв цена с 10 точки с BILLA Card -35% 264.00 лв цена без точки без BILLA Card 150.00лв цена с 10 точки с BILLA Card -43% КОМПЛЕКТ ЗА БЪРЗО И ЛЕСНО РАЗПАЛВАНЕ НА ВЪГЛИЩА Weber® (уред+брикети+кубчета) 89.00 лв цена без точки без BILLA Card 52.00 лв цена с 10 точки с BILLA Card -41%
Weber.
изчерпване на
БЕЗАЛКОХОЛНИ
















































могат да бъдат закупени еднократно на обявената цена с отстъпка при едновременно маркиране на каса на дигитален ваучер и BILLA Card. Ваучерите са достъпни в приложението BILLA App и на www.billa.bg. Ограниченията в закупуваните количества и срокът на валидност на офертата са посочени на ваучера. Продуктите могат да бъдат закупени без дигитален ваучер на продажната цена, обявена на етикета в магазина. Отстъпката получаваш веднага на




























Черешово топче 2, ул. Димитър Талев 132А; Бургас, ул. Александровска 58, ж.к. Изгрев, бл. 178, ул. Слънце 30; Варна, ул. Капитан Райчо 101; ул. Д. Икономов 36, ул. Дубровник 46, бул. Кн. Борис I 99; Русе, ул. Н. Бозвели 18, пл. Свобода 7; Ст. Загора, ул. Кн. Борис 93, бул. Цар Симеон Велики 105 А; Хасково, пл. Общински 3; Плевен, пл. Свобода 25; Кюстендил, ул. Пауталия 10; В. Търново, ул. Г. Измирлиев 13А; Монтана, ул. Акад. И. Дуриданов 2; Кърджали, кв. Възрожденци, ул. Баба Тонка 24, Созопол, ул. Републиканска 5.


ВЕЧЕ И С НАШИТЕ МАРКИ
РАН Е
3X
НЕДЕЛЯ * Офертата е валидна от 21.07.2023 г. до 23.07.2023 г. или до изчерпване на наличните количества. Само с BILLA Card. Офертата не се прилага за продукти от седмични акции (червени цени), артикули с етикет „Сега в BILLA“, както и за други стоки с намалени цени. Отстъпката получаваш веднага на каса. Изображенията са илюстративни.
ВСИЧКИ
НАЦИОНАЛЕН ТЕЛЕФОН НА КЛИЕНТА 0700 120 10 СВЪРЖИ СЕ С НАС НА ЦЕНАТА НА ЕДИН ГРАДСКИ РАЗГОВОР Събирайте използваната хартия за рециклиране. Всички оферти са валидни до изчерпване на количествата, като стоките се продават в количества, предназначени за домакинството. Посочените цени са в български лева с включен ДДС. BILLA не носи отговорност за допуснати печатни грешки. BILLA си запазва правото да променя цените. Повече на www.billa.bg С този знак се обозначават продукти,
каса. Повече в BILLA App и на www.billa.bg. С този знак се означават продукти, които не са налични в магазини BILLA: София, бул. Цариградско шосе 12, бул. Цар Освободител 22, ул. Раковски 116, пл. Лъвов мост 2, ул. Пиротска 9, бул. Кн. Ал. Дондуков Корсаков 11, ул. В. Белински 2Б, ул. Славянска 5, ул. П. Зографски 38, ул. Р. Алексиев 40, бул. Ал. Стамболийски 247-В; Пловдив, ул. Р. Даскалов 8, ул.
-25%
ОФЕРТА
ПЕТЪК21.07.-23.07. -
НА ВСИЧКИ
КАШКАВАЛИ*
НА
СОКОВЕ, ГАЗИРАНИ
НАПИТКИ
И ВОДИ* НА ВСИ КИ БИСКВИТИ*
които

























































































































































Посочените цени са в български лева с включен ДДС. -41% 2799 Кафе на зърна Lavazza Crema e Aroma 1 кг 4799 -29% 2249 Ирландско уиски Tullamore D.E.W. 0,7 л 3199 -35% 089 Кисело мляко 2% Саяна 400 г 139 -21% 109 Кроасан Lotto 110 г 139 -35% 449 Кюфтета или кебапчета от свинско месо 480 г 699 -28% 429 Обикновени вафли Боровец 630 г 599 -50% 1599 Гел за пране Perwoll Renew Black 2,7 л 48/54 пранета 3199 -33% 199 Пъпеш деликатесен Произход - България 1 кг 299 -35% 1099 Варенопушено свинско филе Соколово От деликатесната витрина За 1 кг 1699 -20% 199 Печен бекон От топлата витрина 1 бр. 249 -50% до
ПН 24.07.25.07. ВТ 26.07. СР 24.07. -16% 149 Брашно Класик София Мел 1 кг 179
Супер ОФЕРТИСТАРТ